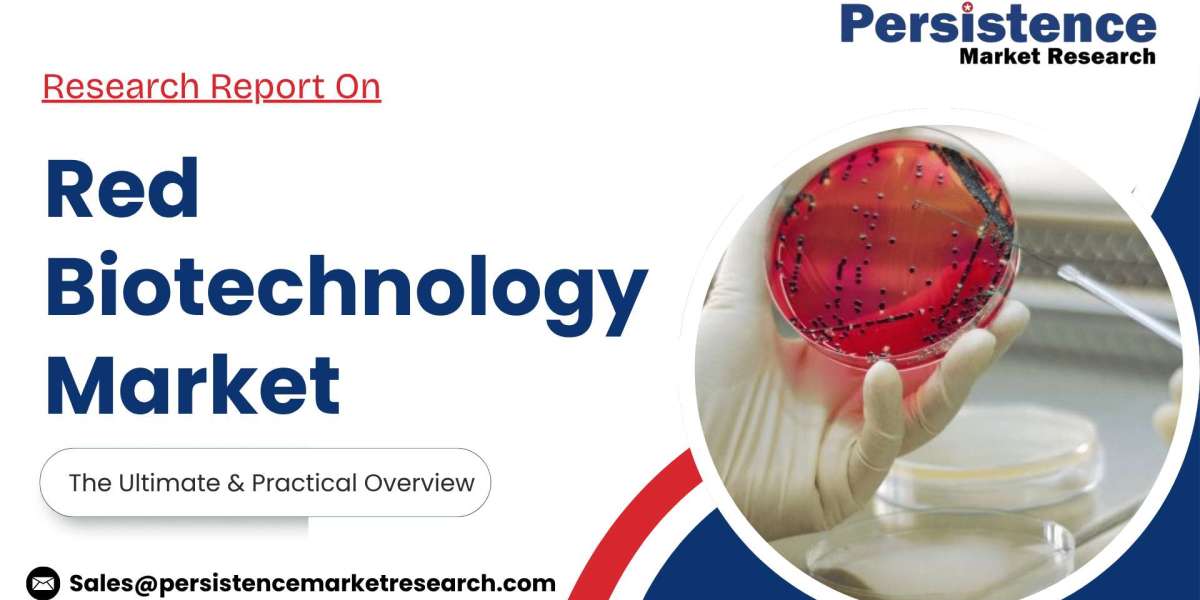
Article Picture

Introduction
Looking to explore everything about Bandra, from its past to present-day glitz and celebrity house in bandra real estate relevance? Here’s a complete guide that walks you through its history, luxurious celebrity homes, lifestyle advantages and drawbacks, property landscape, and iconic landmarks.
Bandra's Rich Historical Tapestry
Bandra, once a sleepy coastal village, has witnessed a dramatic transformation over the centuries. The roots of this suburb trace back to the Portuguese era in the 16th century when it was known as “Bandora.” The Portuguese influence is still visible today through its beautiful churches, narrow lanes, and charming villas.
Later, under British rule, Bandra began its urban journey. With the introduction of the railways and the establishment of Bandra station in 1867, the area became accessible and attractive to the elite. It evolved into a sought-after suburb, housing communities of East Indians, Goans, and Parsis.
Bandra has preserved its historical identity with landmarks like Mount Mary Church and St. Andrew’s Church—both colonial-era churches that are still active centers of community life. The Bandra Fort and surrounding promenades further reinforce its historic charm, offering scenic views of the Arabian Sea while echoing stories of the past.
Celebrity Homes in Bandra
Home to India’s biggest film stars, cricketers, and industrialists, Bandra has earned the moniker of Mumbai’s “star district.” The idea of residing close to a celebrity house in bandra is more than just a fantasy—it’s a reality for those who call this elite suburb home.
Carter Road, Pali Hill, and Bandstand are some of the most coveted zones where luxurious bungalows and designer apartments line the lanes. These residences are often equipped with private gyms, elevators, infinity pools, home theatres, and more—offering unmatched privacy and opulence.
Living in Bandra means sharing space with the country’s most influential names. Yet despite the spotlight, the suburb maintains a sense of intimacy and community. Security, comfort, and accessibility blend seamlessly here.
The charm of walking past a house and knowing a national icon lives behind those walls adds emotional value to property ownership in Bandra. This allure consistently boosts demand in the local real estate market.
Pros of Living in Bandra
Bandra’s appeal goes far beyond fame. Here are ten strong reasons why people love living in this iconic suburb:
Cultural Fusion – Bandra is a perfect blend of Portuguese, British, and Indian cultures.
Vibrant Lifestyle – Fashion streets, nightlife, and gourmet cafés make it Mumbai’s liveliest suburb.
Proximity to Work Hubs – Easy access to BKC, Andheri, and South Mumbai.
Elite Neighbourhoods – Live among celebrities, entrepreneurs, and NRIs.
Scenic Beauty – Sea views, promenades, and green parks offer a peaceful living experience.
Top Education Institutes – Schools and colleges like St. Stanislaus and Rizvi College are within reach.
Healthcare Access – World-class hospitals like Lilavati are right around the corner.
Well-Connected – Roads, railways, and flyovers ensure seamless movement.
Heritage Charm – Colonial buildings and old churches lend historical depth.
Creative Energy – Public murals, wall art, and indie events create an inspiring atmosphere.
Cons of Living in Bandra
Even with all its glam, Bandra has a few downsides that potential residents should consider:
High Property Prices – Premium location comes with premium costs.
Traffic Bottlenecks – Narrow roads lead to frequent jams.
Parking Troubles – Limited space in older localities.
Construction Chaos – Ongoing redevelopment can disturb the peace.
Monsoon Woes – Some areas face waterlogging.
Overcrowded Weekends – Cafés and promenades get packed.
Noise Pollution – From nightlife to festivals, silence is rare.
Limited Open Land – Scarcity of large plots for new projects.
Expensive Rentals – Tenants need a higher budget to live here.
Humidity Levels – Coastal climate leads to sticky summers.
Despite these cons, the advantages far outweigh them, which is why Bandra remains a top pick for both end-users and investors.
Real Estate Overview
Bandra’s real estate market is marked by limited supply and sky-high demand. Whether it’s a heritage bungalow or a luxury apartment, every square foot here is aspirational. Developers are constantly reinventing old buildings into boutique residential towers while preserving Bandra’s aesthetic value.
The demand for sea-facing flats and penthouses is high among HNIs, NRIs, and even foreign nationals. Pali Hill, in particular, remains one of the most exclusive micro-markets in all of Mumbai.
Due to the consistent demand and iconic location, properties in Bandra rarely stay on the market for long. Investors see long-term capital appreciation, while families see unmatched lifestyle benefits.
From compact premium homes to expansive celebrity-style villas, Bandra offers a wide real estate spectrum with elite positioning. While prices are best discussed with real estate advisors, one thing is certain—Bandra is a premium investment.
Key Landmarks in Bandra
Bandra is not just a residential and celebrity hotspot—it’s a landmark-laden cultural zone. Here are some of its most iconic destinations:
Mount Mary Church – A 400-year-old religious landmark known for the annual Bandra Fair.
Bandra Fort – Overlooks the Bandra-Worli Sea Link, ideal for evening strolls.
Bandra-Worli Sea Link – Mumbai’s architectural marvel that connects Bandra to South Mumbai.
Carter Road Promenade – Perfect for jogging, dog-walking, and sunset views.
Bandra Bandstand – A leisure and romantic hotspot, famous for celebrity sightings.
Linking Road – A shopping paradise filled with everything from street fashion to designer labels.
Chimbai Village – A small fishing hamlet that showcases Bandra’s original roots.
Ranwar Village – One of the oldest settlements with wall art and indie cafés.
Jogger’s Park – A beautifully maintained public park with a seaside running track.
St. Andrew’s Church – A Roman Catholic church dating back to 1575, rich in architecture and heritage.
Lifestyle in Bandra
Living in Bandra is more than owning a home—it's about experiencing a culture. Art galleries, music gigs, film festivals, and community events keep the suburb lively all year round. It is a hub for creative professionals, digital nomads, and global citizens.
Street art by local and international artists adds vibrancy to the walls. Rooftop cafés, beach-view restaurants, and cozy bars offer the best of Mumbai’s social life. Fitness enthusiasts benefit from yoga studios, gyms, and cycling paths spread throughout the neighborhood.
This mix of luxury, art, and community is what makes Bandra truly unique.
10 FAQs About Bandra (With One-Line Answers)
Is Bandra a good place to live?
Yes, Bandra offers a premium lifestyle with excellent amenities and heritage charm.Who are some celebrities living in Bandra?
Several Bollywood stars, cricketers, and artists reside in Bandra’s premium localities.Is Bandra expensive for property buyers?
Yes, Bandra is one of the costliest real estate markets in Mumbai.What are the best areas in Bandra?
Pali Hill, Carter Road, Bandstand, and Mount Mary Road top the list.Does Bandra have sea-facing apartments?
Yes, especially along Carter Road and Bandstand.Is Bandra well-connected to South Mumbai?
Absolutely, via the Bandra-Worli Sea Link and road/rail networks.Are there good schools in Bandra?
Yes, Bandra has some of Mumbai’s finest educational institutions.Is parking a problem in Bandra?
Yes, especially in older buildings and lanes.What are the popular hangout spots in Bandra?
Cafés, bars, promenades, and shopping streets.Does Bandra flood during monsoon?
A few areas may experience waterlogging during heavy rains.
Conclusion
Bandra is not just a place—it’s a lifestyle, a vibe, and a cultural legacy. Its unique ability to blend old-world charm with modern luxury makes it one of the most desirable places in Mumbai. From heritage structures and sea-facing promenades to fashion streets and celebrity house in bandra, everything here feels iconic.
While it comes with a premium tag, Bandra offers unmatched value in terms of location, lifestyle, community, and long-term appreciation. For those seeking a home that reflects both tradition and trend, Bandra is the address that has it all. Whether you’re buying for family, investment, or luxury living, this suburb continues to deliver excellence across all fronts.